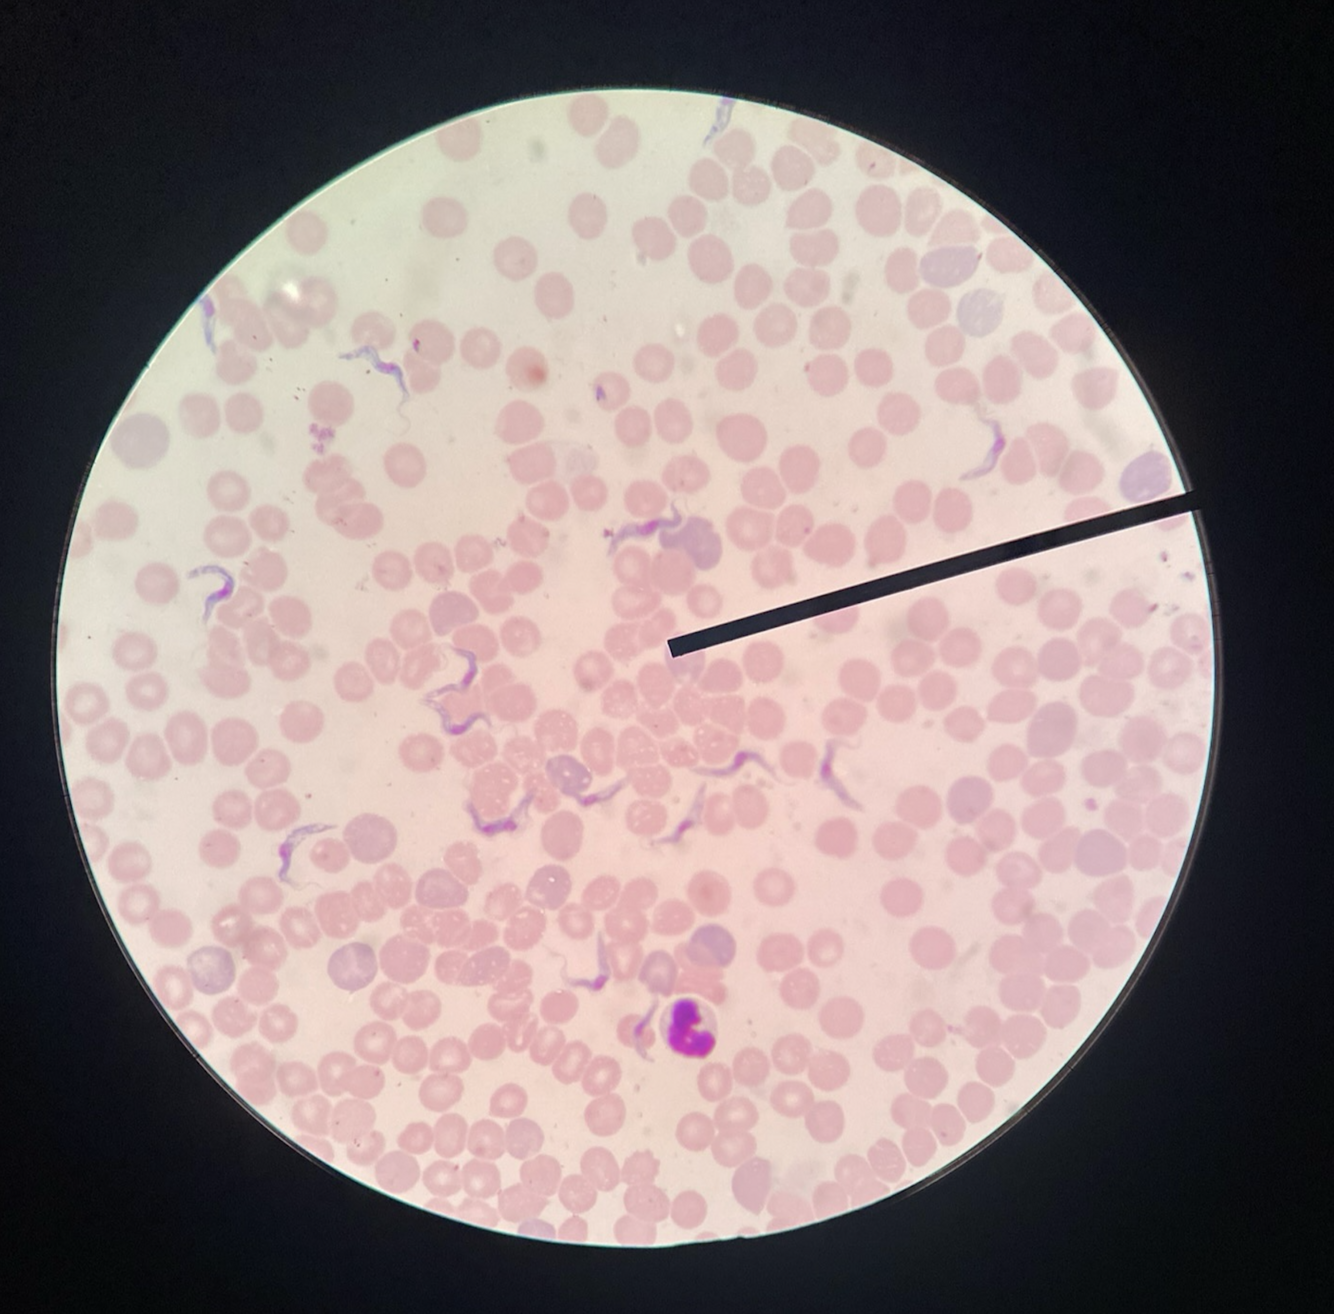

What is the etiologic agent of Chagas Disease?
A) Trypanosoma cruzi
B) Trypanosoma brucei
C) Plasmodium falciparum
D) Leishmania donovani
A) Trypanosoma cruzi
Rationale: Trypanosoma cruzi is the etiological agent of Chagas Disease, also known as American Trypanosomiasis. This parasite is responsible for causing the disease in humans and is transmitted by triatomine bugs.
Which form of Trypanosoma cruzi circulates in the blood and is capable of infecting cells?
A) Epimastigote
B) Amastigote
C) Trypomastigote
D) Promastigote
C) Trypomastigote
Rationale: The trypomastigote form of Trypanosoma cruzi circulates in the blood and is capable of infecting cells. This form allows the parasite to be transmitted to humans by the insect vector and to infect various tissues in the body.
What is the common name for the insect vector responsible for transmitting Trypanosoma cruzi to humans?
A) Anopheles mosquito
B) Sandfly
C) Tsetse fly
D) Triatomine bug
D) Triatomine bug
Rationale: Triatomine bugs, also known as reduviid bugs or kissing bugs, are the insect vectors responsible for transmitting Trypanosoma cruzi to humans. Transmission occurs when the bug defecates while feeding on human blood.
How is Trypanosoma cruzi transmitted to humans by its insect vector?
A) Through the insect’s saliva during biting
B) When the insect defecates while feeding on human blood
C) By inhaling the insect’s eggs
D) Through contaminated water
B) When the insect defecates while feeding on human blood
Rationale: Trypanosoma cruzi is transmitted to humans when triatomine bugs defecate while feeding. The parasite enters the host through the wound created by the bug’s bite or through mucous membranes.
Which species of Trypanosoma causes African Sleeping Sickness?
A) Trypanosoma cruzi
B) Trypanosoma brucei
C) Trypanosoma rangeli
D) Trypanosoma lewisi
B) Trypanosoma brucei
Rationale: Trypanosoma brucei is the causative agent of African Sleeping Sickness. This parasitic species is transmitted by tsetse flies and can infect humans and animals.
T. brucei gambiense is responsible for which form of sleeping sickness?
A) Acute
B) Chronic
C) Both acute and chronic
D) Neither acute nor chronic
B) Chronic
Rationale: T. brucei gambiense causes a chronic form of sleeping sickness, which can last for years without significant signs or symptoms before progressing to affect the central nervous system.
T. brucei rhodesiense causes a form of sleeping sickness that is:
A) Chronic and lasts for years without major signs
B) Acute and can be fatal within months if untreated
C) Mild and often resolves without treatment
D) Asymptomatic
B) Acute and can be fatal within months if untreated
Rationale: T. brucei rhodesiense causes an acute form of sleeping sickness that progresses rapidly. Without treatment, the disease can be fatal within months, highlighting the importance of early detection and treatment.
What is the vector for Trypanosoma brucei?
A) Anopheles mosquito
B) Sandfly
C) Tsetse fly
D) Triatomine bug
C) Tsetse fly
Rationale: The tsetse fly (Glossina spp.) is the vector for Trypanosoma brucei. The fly becomes infected by feeding on the blood of infected animals or humans and can transmit the parasite to other hosts through its bite.
What disease is caused by Leishmania tropica?
A) Visceral Leishmaniasis
B) Cutaneous Leishmaniasis
C) Mucocutaneous Leishmaniasis
D) None of the above
B) Cutaneous Leishmaniasis
Rationale: Leishmania tropica is responsible for Cutaneous Leishmaniasis, characterized by skin lesions that typically ulcerate and can leave scars once healed. This form is prevalent in the Middle East, North Africa, and parts of Asia.
Leishmania braziliensis is known to cause which form of Leishmaniasis?
A) Visceral
B) Cutaneous
C) Mucocutaneous
D) None of the above
C) Mucocutaneous
Rationale: Leishmania braziliensis causes Mucocutaneous Leishmaniasis, starting with skin lesions that can spread and cause destructive damage to mucosal areas, especially the nose and mouth. It is more common in South and Central America.
Which species of Leishmania is associated with Visceral Leishmaniasis, also known as Kala-Azar?
A) Leishmania tropica
B) Leishmania braziliensis
C) Leishmania donovani
D) Leishmania major
C) Leishmania donovani
Rationale: Leishmania donovani causes Visceral Leishmaniasis (Kala-Azar), affecting internal organs like the liver, spleen, and bone marrow. It is the most severe form of the disease and can be fatal without treatment. It is prevalent in parts of Asia, East Africa, and South America.
What are amastigotes in the context of Leishmania parasites?
A) The infective stage found in sandflies
B) The form transmitted through sandfly bites
C) The intracellular form found in humans
D) The form that reproduces within sandflies
C) The intracellular form found in humans
Rationale: Amastigotes are the intracellular form of Leishmania parasites, living within host cells such as monocytes and polymorphonuclear leukocytes. They are characterized by their ovoid, rounded bodies and lack an external flagellum visible under the light microscope.
Promastigotes are recognized by which feature?
A) Lack of a flagellum
B) Presence of a single free flagellum
C) Ability to infect the liver and spleen
D) Absence from the sandfly’s digestive tract
B) Presence of a single free flagellum
Rationale: Promastigotes, the infective stage to humans, are characterized by a single free flagellum arising from the kinetoplast at the anterior end. They are found in the digestive tract of phlebotomine sandflies and are transmitted to humans through the bite of an infected sandfly.
Which insect is the primary vector for Leishmania species in the Old World?
A) Anopheles mosquito
B) Aedes mosquito
C) Phlebotomus spp. sandfly
D) Culex mosquito
C) Phlebotomus spp. sandfly
Rationale: In the Old World, which includes Europe, Africa, and Asia, Phlebotomus sandflies serve as the primary vectors for Leishmania species. These sandflies become infected by feeding on the blood of an infected host and then transmit the parasites to a new host during subsequent blood meals.
What are tachyzoites in the life cycle of Toxoplasma gondii?
A) The form shed in the feces of the definitive host
B) The rapidly dividing form found during the acute phase of infection
C) The form contained within tissue cysts in various organs
D) The environmentally resistant form
B) The rapidly dividing form found during the acute phase of infection
Rationale: Tachyzoites are the rapidly dividing forms of T. gondii that are responsible for spreading the infection throughout the host’s body during the acute phase. They are typically targeted by the immune system to control the spread of the infection.
What does the presence of tissue cysts containing bradyzoites signify in a Toxoplasma gondii infection?
A) The end of the infectious cycle
B) The beginning of the acute phase
C) A long-term, potentially lifelong presence of the parasite in the host
D) Immediate transmission potential to the definitive host
C) A long-term, potentially lifelong presence of the parasite in the host
Rationale: Tissue cysts containing bradyzoites represent a slower-growing form of T. gondii that can remain dormant within the host for life. These cysts can reactivate if the immune system becomes compromised, indicating a long-term presence of the parasite.
Oocysts of Toxoplasma gondii are known for:
A) Rapid division within the host’s body
B) Being the form ingested by cats to become definitive hosts
C) Their environmental resistance and role in transmission to intermediate hosts
D) Sexual reproduction within human hosts
C) Their environmental resistance and role in transmission to intermediate hosts
Rationale: Oocysts are the environmentally resistant forms of T. gondii shed in the feces of the definitive host (cats). They can survive in the environment for extended periods and are a major source of infection for intermediate hosts, including humans, once they become infective after sporulation.
Who are the definitive hosts for Toxoplasma gondii?
A) Humans
B) Rodents
C) Members of the cat family (Family Felidae)
D) Canines
C) Members of the cat family (Family Felidae)
Rationale: Members of the cat family, including domestic cats and other felines, are the definitive hosts for Toxoplasma gondii. This is because only in these hosts can the parasite complete its sexual reproduction cycle, leading to the shedding of oocysts in the feces, which are crucial for the transmission of the parasite.
What is the infective form of Cryptosporidium parvum?
A) Sporozoite
B) Merozoite
C) Oocyst
D) Trophozoite
C) Oocyst
Rationale: The infective form of Cryptosporidium parvum is the oocyst. These are spherical or oval and contain the sporozoites that are the actual infective agents. The oocysts’ unique characteristics, including their resistance to environmental stresses and specific staining properties, are crucial for their identification and role in the transmission of cryptosporidiosis.
How can Cryptosporidium parvum oocysts be identified in stool examinations?
A) They stain well with iodine.
B) They are acid-fast.
C) They have a flagellum visible under the microscope.
D) They are easily crushed under standard microscope slides.
B) They are acid-fast.
Rationale: Cryptosporidium parvum oocysts do not stain with iodine but are acid-fast, allowing for identification with specific staining methods. This characteristic aids in their detection during stool examination and contributes to the diagnosis of cryptosporidiosis.
What makes Cryptosporidium parvum oocysts particularly challenging in terms of environmental survival?
A) Their ability to multiply rapidly outside the host.
B) Their thick wall that makes them resistant to environmental stresses.
C) Their large size which prevents filtration.
D) Their rapid degradation in water.
B) Their thick wall that makes them resistant to environmental stresses.
Rationale: The oocysts have a thick wall that enables them to withstand environmental stresses, including temperatures up to 60°C. This characteristic makes Cryptosporidium parvum a significant public health challenge, particularly in the context of waterborne outbreaks.
Why are Cryptosporidium oocysts resistant to standard chlorination processes used in water treatment?
A) They are too small to be filtered out.
B) They reproduce too quickly for chlorine to be effective.
C) Their thick wall provides resistance.
D) They neutralize chlorine chemically.
C) Their thick wall provides resistance.
Rationale: The thick-walled oocysts of Cryptosporidium are very resistant to standard chlorination processes used in water treatment. This resistance contributes to their ability to cause outbreaks of diarrheal illness through contaminated drinking water.
What disinfection strategy is effective against Cryptosporidium in water supplies?
A) Chlorination alone
B) UV radiation alone
C) Sequential application of ozone and chlorine
D) Boiling for 10 minutes
C) Sequential application of ozone and chlorine
Rationale: Effective elimination of Cryptosporidium from water supplies often requires the sequential application of ozone and chlorine. Ozone is particularly effective at inactivating Cryptosporidium oocysts, and the combination with chlorine provides a robust treatment strategy to ensure the safety of drinking water.
A. Trypanosoma cruzi
B. Trypanosoma brucei
C. Leishmania
D. Toxoplasma gondii
E. Cryptosporidium parvum
A. Trypanosoma cruzi











































